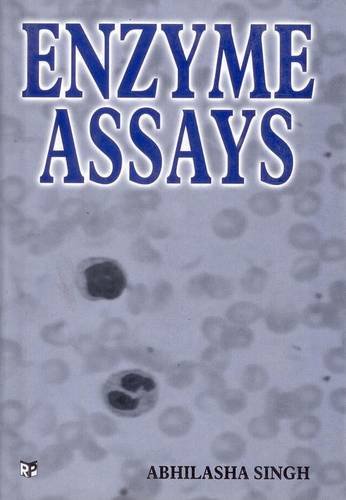

1
/
of
1
Enzyme Assays
Enzyme Assays
Regular price
£68.98 GBP
Regular price
Sale price
£68.98 GBP
Unit price
/
per
Taxes included.
Couldn't load pickup availability
Enzyme Assays
Share
No reviews